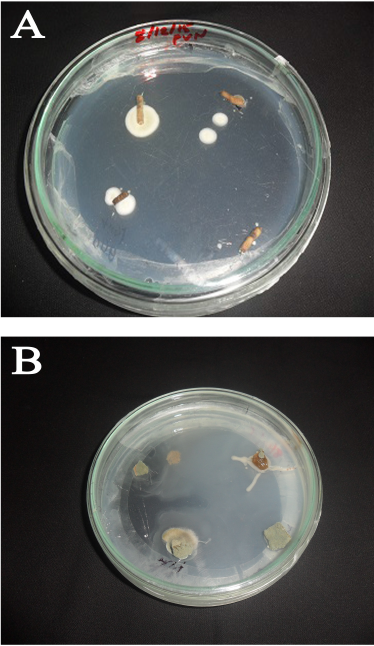

1. INTRODUCTION
Plants do not live alone as single entities rather closely associated with the microorganisms that reside both externally and, especially with those living internally [1]. Multiple microbial communities such as bacteria, archaea, and fungi reside inside healthy plant tissues without producing any prominent disease or clinical symptoms in their host can be considered as endophytes [2]. They devote their entire life or a part of the life cycle in the symplast or apoplast region of healthy plant tissues [2,3]. Endophytes contribute to the overall growth, development, fitness, and diversification of plants [1]. They provide enhanced competitive abilities, increased resistance to herbivores, pathogens, and various abiotic stresses that negatively affect the health and survival of their host [4]. Endophytes are now considered as a repository of novel bioactive natural compounds. There are several recent studies which illustrate the importance of endophytes as a new reserve of antibacterial and other bioactive molecules [5,6]. Over 8,600 bioactive metabolites of fungal origin have been described and it was also reported that they are able to make the same secondary metabolites as the host plant itself [4,7].
The Lagenandra toxicaria Dalz. is a semi-aquatic herb that belongs to the Family Araceae, and is an important ingredient in the folklore treatment modalities. It is used in the preparations of ointments for skin itch, renal and bilious complaints [8]. The L. toxicaria rhizomes and roots were also reported to be diuretic, carminative, tonic, and also used for wound healing. Its rhizomes have also shown insecticidal and antimicrobial properties [9,10]. Another plant under investigation, Kaempferia rotunda L., belongs to the Family Zingiberaceae is commonly known as peacock ginger (Bhuichampaka in Sanskrit), is a fragrant aromatic herb with tuberous rhizome. The plants of the Zingiberaceae Family have been widely used in dietary cuisines and in traditional oriental medications [11]. The K. rotunda extracts are known to contain diverse secondary metabolites such as flavonoids, flavonols, stigmasterol, chalcones, quercetin, β-sitosterol, syringic acid, and protocatechuic acid [12–14]. Several recent studies have also endorsed the fact that K. rotunda possesses a wide range of pharmaceutical activities such as antibacterial, anti-proliferative, anti-mutagenic, and antioxidant activity [15–17]. The current study was designed to isolate the endophytic fungi from these two plants and to evaluate their potential as bio-control agents.
2. MATERIALS AND METHODOLOGY
2.1. Collection and Identification of Plant Material and Their Endophytes
Healthy plants were collected from their natural habitats in different areas of Thrissur District, Kerala, India. Plant materials were subjected to morphological identification at the Department of Botany, University of Calicut, Kerala, India, and voucher specimens are kept (L. toxicaria 7001 and K. rotunda 7002) for reference. Isolation of endophytic fungi were done according to the method described previously by Ezra et al. [18]. Rhizomes of L. toxicaria and K. rotunda were used for the isolation of endophytic fungi. Tissues were washed separately in running water for 10 minutes to remove debris and finally washed with double distilled water to minimize the microbial load from the sample surface. Thin sections of plant parts (approximately 2–3 cm in length) were then subjected to surface sterilization using 0.5% sodium hypochlorite for 3 minutes followed by 70% ethanol for 2 minutes and finally rinsing in sterile distilled water for removing alcohol traces. Tissues were then dried under the sterile laminar air flow. The surface treatment was done adopting the methodology of Petrini et al. [19], and the effectiveness of surface sterilization was checked according to the method of Schulz et al. [20]. The outer tissue layers were removed using sterile scalpel and the internal tissues were cut into smaller pieces of 0.5–1 cm and plated individually in Petri dishes containing potato dextrose agar, to which 0.1% antibiotic solution (stock) was previously added. The potato dextrose agar (PDA) plates were incubated at 25°C for 4 weeks under dark and checked every 24 hours for any fungal growth. Fungal hyphae emerging out of the plant tissues were sub-cultured several times to obtain the pure culture. Isolation procedure was repeated for 10 times to confirm the presence of the same endophyte. Only those endophytic fungi that have been obtained during repeated isolation were further taken for morphological and molecular identification. The phenotypic study was based on the culture characteristics and morphology of spores. Morphological changes such as growth rate, color, color variation over different time periods, upside and down side color of the colonies, and surface texture were observed. Also, microscopic features such as the mycelium, conidiophores, conidia were studied using lactophenol cotton blue staining methods [21].
2.2. Identification of the Endophytes using Molecular Taxonomic Approach
The clone purified fungal cultures were then used for further taxonomic studies. Ribotyping targets, especially the large-subunit rDNA gene (D1–D2) have shown particular promise for the molecular identification of fungi. The D1/D2 region was amplified by polymerase chain reaction (PCR) from fungal genomic DNA using PCR universal primers: DR–5′-GGTCCGTGTTTCAAGACGG-3′ and DF-5′-ACCCGCTGAACTTAAGC-3′. The amplicon was subjected to automated DNA sequencing on ABI3730xl Genetic Analyzer (Applied Biosystems, Bedford, MA). Each nucleic acid sequence was verified manually to correct any falsely identified bases and trimmed to remove unreadable sequences at both 3′and 5′ ends (considering peak and quality values for each base) using the sequence analysis tools. The edited sequences were then used for similarity searches using BLAST program in the NCBI GenBank DNA database for identification of the fungal strain.
2.3. Fermentation and Solvent Extraction of Endophytes
The isolated colonies were cultured in Potato Dextrose Broth for 2 weeks. These fermented broths were then repeatedly extracted with the same volume of ethyl acetate. The solvent extracts were then combined and evaporated to dryness by a rotary evaporator (KNF Rotary evaporator RC 600) giving a final yield of about 0.8%–1.1% [3].
2.4. HPLC Mediated Polyphenol Profiling of the Extracts
Polyphenol profiling and quantification was executed using the high-performance liquid chromatography (HPLC) method proposed by Rodriguez-Delgado et al. [22], with minor modifications. The analysis was performed on a Prominence UFLC system (Shimadzu, Japan) containing LC-20AD system controller, Phenomenex Gemini C18 column (250 × 4.6 mm, 5 µm), a column oven (CTO-20A), a Rheodyne injector (USA) with a loop of 20 µl volume and a diode array detector (SPD-M20A). The solutions of K. rotunda rhizome extracts and the reference compounds (1 mg/ml) were filtered through 0.45 µl polytetrafluoroethylene filter; 20 µl was injected into the HPLC system. Sample peaks were identified by comparing with retention times of standard peaks.
2.5. Antibacterial Studies
2.5.1. Disk diffusion
The isolated endophytic fungi were evaluated for their antibacterial activity against seven strains of bacteria (Escherichia coli, Klebsiella pneumoniae, Staphylococcus aureus, Shigella flexneri, Serratia marcescens, Bacillus cereus, and Enterococcus faecalis). The antibacterial effect of the extract obtained from endophytic fungi was tested by a modified agar disc diffusion assay [23] with paper disks. The isolated endophytic fungi were evaluated for their antibacterial activity against seven strains of bacteria (E. coli, K. pneumoniae, and S. aureus). The fermented broths were extracted with the same volume of ethyl acetate. The extracts were then combined and evaporated to dryness by a rotary evaporator (KNF Rotary evaporator RC 600) giving a final yield of about 0.8%–11% [3]. The collected crude extract was weighed and finally dissolved in 1% dimethylsulfoxide (DMSO) and diluted to 50 µg/µl for assay. A sterile paper disc (6 mm diameter, Whatman no. 1) was impregnated with 10 µl of 1% DMSO dissolved culture filtrate using a micropipette and kept under a laminar hood for 20 minutes to dryness. The air-dried paper discs containing 0.5 mg crude extract were used to test the activity against three strains of bacteria. The bacterial suspension (100 μl) from overnight broth culture, adjusted to contain 1 × 108 colony-forming unit (CFU)/ml of bacteria was spread by a sterile glass rod onto the surface of solidified Mueller-Hinton Agar Petri plates. The paper discs containing 0.5 mg crude extract were placed on the surface of the Mueller-Hinton Agar medium seeded with test bacterium in separate Petri plates. The paper disc dried after impregnating with only 1 % DMSO of the same volume was considered as vehicle control. The reference antibiotic discs were amoxicillin (10 µg/disc) and tetracycline (5 µg/disc). The plates were incubated at 35°C ± 2°C for 24 hours and the degree of sensitivity was determined by measuring the zone of bacterial growth inhibition [23]. Each test was done in three replicates.
2.5.2. Broth microdilution assay
Broth microdilution assay was executed for the determination of minimum inhibitory concentration (MIC). The assay was executed according to the method proposed by Wiegand et al. [24] and Bussmann et al. [25] with slight modifications. Endophytic fungal extracts were serially diluted in sterile Muller-Hinton broth (MHB) to obtain an initial concentration range from 12 to 0.023 mg/ml. The assay was executed in sterile 96-well microtiter plates. The 1–10 wells (test) of each row were filled with 500 µl of endophytic fungal extracts dissolved in sterile MHB. The 11th column served as growth control well and 12th column served as sterility control well. The sterility control wells received 1,000 µl sterile MHB alone, whereas growth control wells received 500 µl sterile MHB containing standard antibiotics such as tetracycline in an initial concentration 5 μg/ml against gram positive strains and amoxicillin in an initial concentration 16 μg/ml against gram negative strains. Inoculated each well containing endophytic fungal extracts (1–10) and growth control well with 500 µl of the bacterial suspension. This results in the desired bacterial inoculum of 5 × 105 CFU/ml. Now the final concentration of endophytic fungal extracts ranges from 6 to 0.011 mg/ml (wells 1–10). Final concentration of the standard antibiotic in the growth control well changes to 0.25 and 8 μg/ml for tetracycline and amoxicillin, respectively [24,25].
2.6. Anthelmintic Studies
The anthelmintic potentials of fungal extracts were studied using 1st instar larvae of Haemonchus contortus by in vitro larvicidal assay. First stage H. contortus larvae were obtained by incubating eggs (obtained from infected animals) at 27°C for 24 hours. Approximately 100 motile larvae of first instar (L1) were collected in 100 μl water. To this equal volume of serially diluted fungal extracts were added to get a final concentration of 1.25, 2.5, 5, and 10 mg/ml. Albendazole (ABZ) (1 µg/ml) and DMSO (1%) served as positive and vehicle controls, respectively [26]. All samples were then incubated for 24 hours at room temperature. The loss of motility of the larvae after 24 hours of treatment was recorded. A number of larvae found non-motile/dead were counted under a dissecting microscope at 40× magnification [27] to calculate the mortality percentage.
2.7. Statistical Analysis
The data obtained are expressed as mean ± standard error. Data from larval mortality assay were transformed by probit analysis against the logarithm of extract concentration in Statistical Package for the Social Sciences version 5.0.
![]() | Figure 1: Endophytic fungi emerging from (a) L. toxicaria and (b) K. rotunda rhizomes in PDA plates. [Click here to view] |
3. RESULTS
3.1. Isolation and Identification of Endophytic Fungi
Rhizomes from L. toxicaria Dalz and K. rotunda L. were separately processed to investigate the presence of endophytic fungi (Fig. 1). A total of four endophytic fungi were isolated to pure culture from L. toxicaria rhizomes and three from the rhizomes of K. rotunda (Table 1). Among the isolates, two strains from L. toxicaria (LTRO1 and LTRH2) and one strain from K. rotunda (KMPRO2) were identified morphologically and also using molecular techniques. The LTRO1 strain was able to develop an aspergillum-like-spore bearing structure. They possess septate hyphae with conidiophores, hyaline and are smooth-walled. The LTRH2 strain appears cinnamon in color with rough conidia and white mycelium on PDA culture. KMPRO2 Conidiophores were heavy-walled, pale green colored, coarsely roughened and approximately 1 mm in length. Also, the phialides appeared biseriate. Alongside the cultural characteristics, lactophenol cotton blue-stained microscopic images were also used for identification purposes. The rDNA gene sequences of the three were done and compared with the sequences in Genbank by blast analysis. Based on the D1/D2 Region-PCR analysis, the nucleotide sequence of the fungal culture LTRO1 showed 100% homology with Aspergillus niger and LTRH2 showed 100% similarity with Aspergillus tamarii. The isolate from K. rotunda (KMPRO2) showed 100% homology with Aspergillus flavus. Therefore, by combined analysis of the fungal morphological characters according to Genera of Hyphomycetes (Carmichael 1980), the strains LTRO1 and LTRH2 are identified as A. niger (Genbank accession number: MW684710) and Aspergillus tamari, respectively (Genbank accession number: MW684711). The strain KMPRO2 is identified as A. flavus (Genbank accession number: MW684712).
![]() | Table 1: Endophytic fungi isolated from rhizomes of L. toxicaria and K. rotunda. [Click here to view] |
![]() | Table 2: Antibacterial activity of crude plant rhizome extract and isolated endophyte extracts (0.5 mg/disk) against different bacteria. [Click here to view] |
3.2. HPLC Mediated Polyphenol Profiling of the Extracts
Qualitative phytochemical characterization of the extracts showed the presence of a high amount of phenolic compounds compared to other secondary metabolites. Therefore, the polyphenol content in the rhizome as well as in the endophyte extracts of L. toxicaria and K. rotunda was estimated using high-performance liquid chromatography. Thirteen standards of polyphenolic compounds; gallic acid, catechol, chlorogenic acid, caffeic acid, syringic acid, p-coumaric acid, ferulic acid, ellagic acid, myricetin, cinnamic acid, quercetin, kaempferol, and apigenin were initially analyzed by HPLC at 1 mg/ml concentration. Retention time was noted and later used for the identification of these molecules in the extracts. The phenolic compounds detected were reconfirmed and quantified by spiking with the individual standards. It was observed that several of the compounds were present in both the ethyl acetate extracts of rhizome and its endophyte isolates. Though L. toxicaria rhizome extracts showed the presence of eight phenolic compounds, only myricetin and ellagic acid was present in a considerable amount (≥ 0.5 mg/g). One of the endophyte isolates of L. toxicaria, LTRH2, had a very similar result whereby, other than myricetin and ellagic acid, only kaempferol was present in a considerable amount. Further, only apigenin was found in higher amounts in the other endophyte, LTRO1 (Table 6). As compared to this, K. rotunda was richer in polyphenolic contents. The rhizome extracts had a considerable quantity of quercetin and cinnamic acid other than myricetin, and ellagic acid (Table 7). Furthermore, KMPRH1, the endophyte isolate of K. rotunda, was having a considerable amount of syringe acid other than myricetin and ellagic acid. Of the total extract samples studied, KMPRO2 showed the presence of highest polyphenolic abundance. The ethyl acetate extracts of KMPRO2 were abundant in myricetin, kaempferol, ellagic acid, syringic acid, ferulic acid, coumarin acid, and caffeic acid.
![]() | Table 3: MIC of endophytic fungal extracts against different bacterial strains. [Click here to view] |
![]() | Table 4: Mortality percentage to H. contortus (L1) larvae by extract treatment. [Click here to view] |
![]() | Table 5: LC50 and LC90 values for H. contortus larval mortality by endophytes using probit analysis. [Click here to view] |
3.3. Antibacterial Activity of Endophytic Fungi
3.3.1. Disk diffusion assay
Culture extracts of all the four endophytic fungi from L. toxicaria and all the three endophytes from K. rotunda were tested for antibacterial activity by disc diffusion assay against seven strains of bacteria (E. coli, K. pneumoniae and S. aureus, K. pneumoniae, Shigella flexneri, S. marcescens, B. cereus, and E. faecalis). Of the four isolates from L. toxicaria, LTRH2, LTRH1, and LTRO1 extracts inhibited five out of seven pathogenic bacteria including both Gram positive and Gram negative strains (Table 2). The LTRH2 extracts exhibited a zone of inhibition of 22.66 ± 0.71 mm against S. aureus and 20 ± 0.48 mm against E. faecalis (Both are Gram positive strains). The zone of inhibition was 15.5 ± 0.22 mm against the Gram negative bacteria, E. coli (Table 2). The activity of LTRH2 was followed by LTRO1, which also exhibited inhibitory activity against all the three bacterial strains tested. In the case of fungal isolates from K. rotunda, KMPR02 and KMPRH1 extracts inhibited five out of seven bacterial strains. Also prominent activity was observed against Gram positive strains. In general, two Gram negative bacterial strains S. flexneri and S. marcescens showed strong resistance against the fungal extracts. None of the tested extracts were effective against these Gram negative bacteria. On the other hand, S. aureus was found to be most susceptible and was found to be inhibited by majority of the endophytic fungal extracts.
3.3.2. Broth microdilution assay
Table 3 shows the MICs of the endophytic fungal extracts from L. toxicaria and K. rotunda against Gram-positive and Gram-negative pathogenic bacteria. Among the fungal extracts of L. toxicaria rhizome, the LTRH2 showed the lowest MIC value of 1.5 mg/ml against S. aureus. Against other Gram-positive strains B. cereus and E. faecalis, the LTRH2 extracts exhibited the MIC values of 3 mg/ml (Table 3). The LTRO1 also showed strong antibacterial efficacy against S. aureus. In the case of fungal isolates from K. rotunda, the least MIC value was obtained with the KMPRH1 extract followed by KMPRO2 extract against S. aureus. All the other extracts showed MIC values ≥ 6 mg/ml concentration (Table 3). The very high MIC values against many strains indicate only a very limited antibacterial potency. In general, Gram positive bacteria showed some susceptibility to the fungal extracts, whereas the Gram negative bacterial strains showed high resistance against the endophytic fungal extracts.
![]() | Table 6: Estimation of different polyphenols in ethyl acetate extracts of L. toxicaria rhizome and its endophytes. [Click here to view] |
![]() | Table 7: Estimation of different polyphenols in ethyl acetate extracts of K. rotunda rhizome and its endophytes. [Click here to view] |
3.4. Anthelmintic Activity
In vitro larval mortality assay envisaged the potential of extracts from endophytic fungi in causing mortality to the 1st instar H. contortus larvae. Two isolates from L. toxicaria (LTRO1 and LTRH2) and two isolates from K. rotunda (KMPRO2 and KMPRH1) were tested using this assay and all the four extracts showed significant dose dependent mortality to the L1 larvae. At the highest test concentration (10 mg/ml), LTRH2 exhibited 92.42 ± 0.52 percent mortality and LTRO1 showed a mortality of 80.50 ± 1.17 percent mortality (Table 4). The isolates from K. rotunda were found effective against the H. contortus larvae with a maximum mean percent mortality of 92.37 ± 0.97 and 90.30 ± 0.51, respectively, with the extracts of KMPRH1 and KMPRO2 isolates at this concentration. The mortality induced by these four fungal extracts was statistically significant (p ˃ 0.001) at all the tested concentrations when compared with vehicle control. The lethal concentration required to induce 50% (LC50) and 90% (LC50) mortality to H. contortus larvae was calculated by probit analysis and is shown in Table 5. Crude extracts of LTRO1 induced 50% lethality at 3.672 mg/ml, whereas LTRH2 showed 50% larval mortality at 2.038 mg/ml. In the case of K. rotunda, the KMPRH1 and KMPRO2 extracts showed LC50 values of 2.443 mg/ml and 2.631 mg/ml, respectively, with 24 hours treatment. Commercially available anti-worm medication, ABZ treatment also caused significant mortality to L1 larva and we obtained 100% larval mortality with 1 µg/ml ABZ treatment. Probit analysis showed an LC50 value of 0.23 µg/ml and LC50 value of 0.78 µg/ml for this larvicidal assay (Table 5) in our experimental system.
4. DISCUSSION
Many previous studies have reported the occurrence of fungal endophytes of medicinal importance inside different regions of medicinal plants [28,29]. The present study was carried out to isolate, identify, and evaluate the antibacterial and nematicidal potentials of endophytic fungi from L. toxicaria Dalz and K. rotunda L. rhizomes. Remarkably we have isolated a total of four and three endophytic fungi from the rhizomes of L. toxicaria and K. rotunda, respectively. Based on morphological and molecular studies, LTRH2 and LTRO1 isolated from L. toxicaria were identified as A. tamarii and A. niger, respectively. The KMPRO2 isolated from K. rotunda was identified as A. flavus. The genus Aspergillus belongs to the Family Trichocomaceae of Order Eurotiales in the Class Eurotiomycetes of Phylum Ascomycota [30]. Tawfike et al. [31] earlier reported the presence of Ascomycetes inside plant tissues. Aspergillus genus is a ubiquitous fungus that is pathologically as well as therapeutically important [32]. Disk diffusion and Broth micro dilution assays were used to determine the antibacterial potentials of endophytic fungi isolated from both plants. Strong antibacterial activity was demarcated as MIC Ë‚ 5 mg/ml [25]. The LTRH2 (A. tamarii), isolated from L. toxicaria, was the most effective endophyte among others to control bacterial growth of both Gram-positive and Gram-negative strains, followed by LTRO1 (A. niger). The inhibitory potentials of A. tamarii against Gram-positive bacteria S. aureus, E. faecalis, and B. cereus were found high compared to Gram-negative strains E. coli and K. pneumoniae. A. tamarii isolated from Lycoperdon umbrium showed similar growth inhibition against Salmonella typhi, S. aureus, Bacillus subtilis, and E. coli in earlier studies [33]. The current study also showed the potential of LTRO1 (A. niger) isolated from L. toxicaria rhizomes against the tested bacteria. A previous study reported the antimicrobial activity of the ethyl acetate extract of A. niger isolated from the stilt rhizomes of Rhizophora apiculata [34]. According to their study, Proteus mirabilis and Pseudomonas aeruginosa were highly sensitive to A. niger extract. Another study testified that A. niger extracts possess aromatic-nitrogenous compound, tensidol which induced high inhibition against P. aeruginosa, S. aureus, Staphylococcus epidermidis, and Bacillus sp. [35]. Further studies are in progress to confirm the presence of tensidol in our endophytes. In the case of K. rotunda, KMPR02 (A. flavus) and KMPRH1 (unidentified) isolates showed effective inhibition against both Gram-positive and Gram-negative bacterial strains. Derivation of two furan compounds, namely 5-acetoxymethyl furan-3-carboxylic acid and 5-hydroxymethyl furan 3-carboxylic acid by the fermentation of A. flavus, isolated from Cephalotaxus fortunei and their potent antibacterial activity against S. aureus was reported earlier by Ma et al. [36]. The present study also highlighted the high resistance of two Gram-negative bacterial strains S. flexneri and S. marcescens against endophytic fungal extracts from both plants. None of the endophytic fungal extracts were active against these two Gram-negative bacteria.
The greatest problems encountered during the use of anthelmintics are increasing nematode resistance and slow degradation in the soil [37]. Studies on the use of endophytic fungal metabolites against animal parasitic nematodes are very less. Hence, we decided to extend our studies on the nematicidal activity of the extracts that gave good results in the bactericidal assays Our study clearly envisages the potentials of the ethyl acetate extracts from A. tamarii, A. niger, A. flavus and KMPRH1 cultures in causing significant larvicidal activities against nematode larvae. A concentration-dependent increase in the death toll of nematode larvae was observable with all the tested extracts.
In the frequent search by the pharmaceutical industry for drug leads, natural resources, particularly plants seem to be a precious repository. Phenols and terpenoids are indeed considered as safe alternatives to commercial anthelmintic drugs and several studies have explained the importance of plant derived flavonoids against worms [38]. Flavonoids such as genistein, quercetin, and kaempferol induced high mortality to nematodes and trematodes in several earlier studies [39,40]. In order to identify and characterize the polyphenolic compounds of fungal extracts, we took the advantage of HPLC analysis. The HPLC studies of our extracts confirmed the presence of at least six different phenolic compounds in a considerable quantity. It was further revealed that the pattern of presence of these molecules was comparable between the rhizome and its endophytes. Myricetin was the most abundant molecule in both rhizomes extract and the endophyte extracts. Kaempferia rotunda rhizome, which is known for its aroma, was having higher polyphenolic content so also its endophyte isolates. Out of the nine polyphenolic molecules detected, four of them having more than 0.5 mg per gram of the extract were identified in both rhizome and endophyte extracts. On the other hand, in L. toxicaria rhizome, only myricetin and ellagic were present in considerable amounts, which is also true for its endophytes. The molecular mechanism of the observed biological activity is not known from this study. But the presence of these phenolic molecules in the crude plant extracts as well as in the newly isolated endophytes indeed give us an alternative source for these molecules. Further bio-guided fractionation studies are needed to identify the individual components and this can lead to the isolation of the active ingredients from this new source.
5. CONCLUSION
In fact, this is the first report on the isolation, identification, and bioactivities of endophytic fungi from L. toxicaria and K. rotunda. Fascinatingly, the present study results provide a solid platform for the development of novel anthelmintic and antimicrobial agents from endophytic fungi of L. toxicaria and K. rotunda. It is noteworthy that endophytic fungi, among the novel biotypes, are in the top priorities now, which would make drastic changes to medicinal, pharmaceutical, and agriculture industries in the future.
6. ACKNOWLEDGMENTS
This study was partially supported by the Kerala State Council for Science, Technology, and Environment, (KSCSTE) Govt. of Kerala. Letter No. 1185/2015/KSCSTE.
Author Praveen Krishnakumar is a Senior Research Fellow of Council of Scientific and Industrial Research, (CSIR) New Delhi, India. Letter No. 08/376 (0014)/2018 EMR-1.
We acknowledge Dr. Moncey Vincent, Dept. of Zoology, Sacred Heart College, Thevara, Ernakulam, Kerala, India for helping in the blast analysis. We also acknowledge Dr. Nisha, Mr. Billu and Mrs. Shini Agro Processing and Technology Division, National Institute for Interdisciplinary Science and Technology (CSIR-NIIST), Thiruvananthapuram, Kerala, India for the HPLC analysis.
7. AUTHOR CONTRIBUTIONS
All authors made substantial contributions to conception and design, acquisition of data, or analysis and interpretation of data; took part in drafting the article or revising it critically for important intellectual content; agreed to submit to the current journal; gave final approval of the version to be published; and agree to be accountable for all aspects of the work. All the authors are eligible to be an author as per the international committee of medical journal editors (ICMJE) requirements/guidelines.
8. CONFLICTS OF INTEREST
The authors report no financial or any other conflicts of interest in this work.
9. ETHICAL APPROVALS
This study does not involve experiments on animals or human subjects.
REFERENCES
1. Hardoim PR, Van Overbeek LS, Berg G, Pirtila AM, Compant S, Campisano A, et al. The hidden world within plants: ecological and evolutionary considerations for defining functioning of microbial endophytes. Microbiol Mol Biol Rev 2015; 79:293–320. CrossRef
2. Andrews JH, Hirano SS. Microbial ecology of leaves. Springer Science & Business Media, Berlin, Germany, 2012.
3. Gond SK, Mishra A, Sharma VK, Verma SK, Kumar J, Kharwar RN, et al. Diversity and antimicrobial activity of endophytic fungi isolated from Nycanthes arbor-tristis, a well-known medicinal plant of India. Mycoscience 2012; 53:113–21. CrossRef
4. Singh LP, Gill SS, Tuteja N. Unravelling the role of fungal symbionts in plant abiotic stress tolerance. Plant Signal Behav 2011; 6:175–91. CrossRef
5. Xie J, Wu YY, Zhang TY, Zhang MY, Peng F, Lin B, et al. New antimicrobial compounds produced by endophytic Penicillium janthinellum isolated from Panax notoginseng as potential inhibitors of FtsZ. Fitoterapia 2018; 131:35–43; doi:10.1016/j.fitote.2018.10.006 CrossRef
6. Wu YY, Zhang TY, Zhang MY, Cheng J, Zhang YX. An endophytic Fungi of Ginkgo biloba L. produces antimicrobial metabolites as potential inhibitors of FtsZ of Staphylococcus aureus. Fitoterapia 2018; 128:265–271; doi:10.1016/j.fitote.2018.05.033 CrossRef
7. Verma VC, Kharwar RN, Strobel GA. Chemical foundation diversity of natural products from plant associated endophytic fungi. Nat Prod Commun 2009; 4:1511–32. CrossRef
8. Chopra RN, Chopra IC, Honda KL, Kapur LD. Indigenous drugs of India. 2nd edition, B. K. Dher of Academic Publishers, Calcutta, India, pp 580, 1994.
9. Sivarajan VV, Indira B. Ayurvedic drugs and their plant sources. Oxford & IBH Publishing Co, Delhi, India, p 570, 1994.
10. Selvakumari PAS, De Britto AJ. Lagenandra toxicaria – A potential medicinal herb for its antimicrobial activity, Proceedings of the National Conference on the frontiers of Research and Development in Medicinal Plants, St. Xavier’s College, Palayamkottai, India, 2004, pp 40–3.
11. Voravuthikunchai SP. Family zingiberaceae compounds as functional antimicrobials, antioxidants, and anti-radicals. Food 2007; 1:227–40.
12. Stevenson PC, Veitch NC, Simmonds MSJ. Polyoxygenated cyclohexane derivatives and other constituents from Kaempferia Rotunda L. Phytochemistry 2007; 68:1579–86; doi:10.1016/j.phytochem.2007.03.015 CrossRef
13. Sulianti SB, Chairul SM. Comparison of volatile oil constituent of two species of Kunci Pepet (Kaempferia Angustifolia Roscue. and K. Rotunda Linn.). Biofarmasi J Nat Prod Biochem 2005; 3:39–42; doi:10.13057/biofar/f030201 CrossRef
14. Diastuti H, Chasani M, Suwandri S. Antibacterial activity of benzyl benzoate and crotepoxide from Kaempferia Rotunda L. rhizome. Indones J Chem 2020; 20:9–15; doi:10.22146/ijc.37526 CrossRef
15. Priya Mohanty JLK, Nath LK, Bhuyan N, Mariappan G. Evaluation of antioxidant potential of Kaempferia rotunda Linn. Indian J Pharm Sci 2008; 70:362–4. CrossRef
16. Atun S, Arianingrum R, Sulistyowati E, Aznam N. Isolation and antimutagenic activity of some flavanone compounds from Kaempferia rotunda. Int J Chem Anal Sci 2013; 4:3–8. CrossRef
17. Kabir SR, Hossen MA, Zubair MA, Alom MJ, Islam MF, Hossain MA, et al. A new lectin from the tuberous rhizome of Kaempferia rotunda: isolation, characterization, antibacterial and antiproliferative activities. Protein Pept Lett 2013; 18:1140–9. CrossRef
18. Ezra D, Hess WH, Strobel GA. New endophytic isolates of M. albus, a volatile antibiotic-producing fungus. Microbiology 2004; 150:4023–31. CrossRef
19. Petrini O, Sieber TN, Toti L, Viret O. Ecology, metabolite production and substrate utilization in endophytic fungi. Nat Toxins 1992; 1:185–96. CrossRef
20. Schulz B, Wanke U, Draeger S, Aust HJ. Endophytes from herbaceous plants and shrubs: effectiveness of surface sterilization methods. Mycol Res 1993; 97:1447–50. CrossRef
21. Gaddeyya G, Niharika PS, Bharathi P, Kumar PKR. Isolation and identification of soil mycoflora in different crop fields at Salur mandal. Adv Appl Sci Res 2012; 3:2020–6.
22. Rodriguez-Delgado MA, Malovaná S, Pérez JP, Borges T, García-Montelongo FJ. Separation of phenolic compounds by high-performance liquid chromatography with absorbance and fluorimetric detection. J Chromatogr 2001; 912:249–57. CrossRef
23. Bauer AW, Kirby WMM, Serris JC, Turck M. Antibiotic susceptibility testing by a standardized single disc method. Am J Clin Pathol 1966; 45:493–6. CrossRef
24. Wiegand I, Hilpert K, Hancock RE. Agar and broth dilution methods to determine the minimal inhibitory concentration (MIC) of antimicrobial substances. Nat Protoc 2008; 3:163; doi:10.1038/nprot.2007.521 CrossRef
25. Bussmann RW, Malca-García G, Glenn A, Sharon D, Chait G, Díaz D, et al. Minimum inhibitory concentrations of medicinal plants used in northern Peru as antibacterial remedies. J Ethnopharmacol 2010; 132:101–8; doi:10.1016/j.jep.2010. 07.048 CrossRef
26. Coles GC, Bauer C, Borgsteede FHM, Geerts S, Klei TR, Taylor MA, et al. World Association for the Advancement of Veterinary Parasitology (WAAVP) methods for the detection of anthelmintic resistance in nematodes of veterinary importance. Vet Parasitol 1992; 44:35–44; doi:10.1016/0304-4017(92)90141-U CrossRef
27. Costa CTC, Bevilaqua CML, Camurca-vasconcelos ALF, Maciel MV, Morais SM, Castor CMS, et al. In vitro ovicidal and larvicidal activity of Azadiracha indica extracts on Haemonchus contortus. Small Rumin Res 2008; 74:284–7. CrossRef
28. Gouda S, Das G, Sen SK, Shin, HS, Patra JK. Endophytes: a treasure house of bioactive compounds of medicinal importance. Front Microbiol 2016; 7:1538. CrossRef
29. Nisa S, Khan N, Shah W, Sabir M, Khan W, Bibi Y, et al. Identification and bioactivities of two endophytic fungi Fusarium fujikuroi and Aspergillus tubingensis from foliar parts of Debregeasia salicifolia. Arab J Sci Eng 2020; 45:4477–87. CrossRef
30. Geiser DM, Gueidan C, Miadlikowska J, Lutzoni F, Kauff F, Hofstetter V, et al. Eurotiomycetes: Eurotiomycetidae and Chaetothyriomycetidae. Mycologia 2006; 98:1053–64. CrossRef
31. Tawfike AF, Tate R, Abbott G, Young L, Viegelmann C, Schumacher M, et al. Metabolomic tools to assess the chemistry and bioactivity of endophytic Aspergillus strain. Chem Biodivers 2017; 14(10). CrossRef
32. Vadlapudi V, Borah N, Yellusani KR, Gade S, Reddy P, Rajamanikyam M, et al. Database, a resource to understand the Secondary metabolome of Aspergillus genus. Sci Rep 2017; 7:2045–322. CrossRef
33. Ogbole OO, Adebayo-Tayo BC, Salawu KM, Okoli VC. Molecular identification and antimicrobial activity of endophytic fungi Aspergillus tamarii (trichocomaceae). Nig J Pharm Sci 2017; 16:41–8.
34. Thorati M, Mishra JK. Antibacterial activity of crude extract from Aspergillus niger isolated from the stilt roots of Rhizophora apiculata along South Andaman coast, India. J Pharmacogn Phytochem 2017; 6:1635–8.
35. Al-Shaibani ABA, Al-Shakarchi FI, Ameen RS. Extraction and characterization of antibacterial compound from Aspergillus niger. J Al-Nahrain Univ 2013; 16:167–74. CrossRef
36. Ma YM, Liang XA, Zhang HC, Liu R. Cytotoxic and antibiotic cyclic pentapeptide from an endophytic Aspergillus tamarii of Ficus carica. J Agric Food Chem 2016; 64:3789–93. CrossRef
37. Scherkenbeck J, Harder A, Plant A, Dyker H. PF1022A – a novel anthelmintic cyclooctadepsipeptide. Modification and exchange of the N-methyl leucine residues. Bioorg Med Chem Lett 1998;8:1035–40. CrossRef
38. Mukherjee N, Mukherjee S, Saini P, Roy P, Babu SP. Phenolics and terpenoids; the promising new search for anthelmintics: a critical review. Mini Rev Med Chem 2016;16(17):1415–41. Available via http://www.ncbi.nlm.nih.gov/pubmed/25723460 CrossRef
39. Rajesh KD, Subramani V, Annamalai P, Nakulan VR, Narayanaperumal J, Solomon J. In vitro study of trematodicidal action of Dicranopteris linearis (Burm.f.) Underw. extracts against Gastrothylax crumenifer. Biomed Pharmacother 2016;84:2042–53. CrossRef
40. Braguine CG, Bertanha CS, Gonçalves UO. Schistosomicidal evaluation of flavonoids from two species of Styrax against Schistosoma mansoni adult worms. Pharm Biol 2012;50:925–9. CrossRef